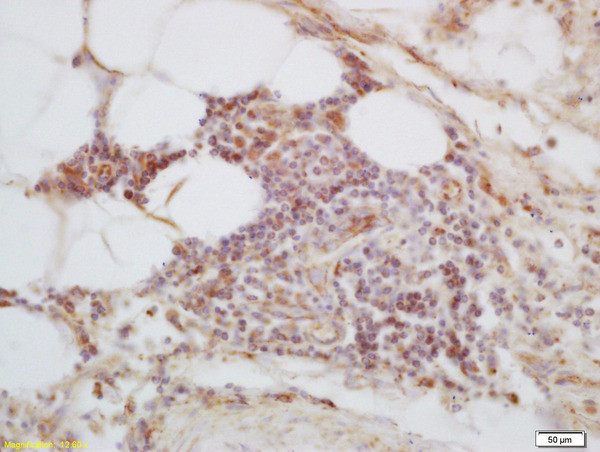
C1orf106 Antibody in Immunohistochemistry (Paraffin) (IHC (P))

Search
Bioss
C1orf106 Polyclonal Antibody
{{$productOrderCtrl.translations['antibody.pdp.commerceCard.promotion.promotions']}}
{{$productOrderCtrl.translations['antibody.pdp.commerceCard.promotion.viewpromo']}}
{{$productOrderCtrl.translations['antibody.pdp.commerceCard.promotion.promocode']}}: {{promo.promoCode}} {{promo.promoTitle}} {{promo.promoDescription}}. {{$productOrderCtrl.translations['antibody.pdp.commerceCard.promotion.learnmore']}}
产品信息
BS-15004R
种属反应
宿主/亚型
分类
类型
抗原
偶联物
形式
浓度
纯化类型
保存液
内含物
保存条件
运输条件
靶标信息
Expressed in peripheral macrophages and intestinal myeloid-derived cells, is required for optimal PRR (pattern recognition receptor)-induced signaling, cytokine secretion, and bacterial clearance. Upon stimulation of a broad range of PRRs (pattern recognition receptor) such as NOD2 or TLR2, TLR3, TLR4, TLR5, TLR7 and TLR9, associates with YWHAQ/14-3-3T, which in turn leads to the recruitment and activation of MAP kinases and NF-kappa-B signaling complexes that amplifies PRR-induced downstream signals and cytokine secretion (PubMed:28436939). In the intestine, regulates adherens junction stability by regulating the degradation of CYTH1 and CYTH2, probably acting as substrate cofactor for SCF E3 ubiquitin-protein ligase complexes. Stabilizes adherens junctions by limiting CYTH1-dependent ARF6 activation (PubMed:29420262). [UniProt]
仅用于科研。不用于诊断过程。未经明确授权不得转售。
篇参考文献 (0)
生物信息学
蛋白别名: Innate immunity activator protein; uncharacterized protein C1orf106 homolog
基因别名: 1700034M08Rik; 4933426C09Rik; AI586180; C1orf106; D1Mgi54; INAVA
UniProt ID: (Mouse) Q7TN12, (Human) Q3KP66
Entrez Gene ID: (Mouse) 67313, (Human) 55765, (Rat) 289399